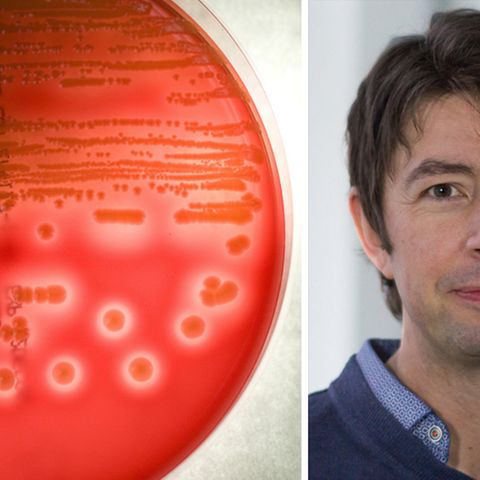

In Österreich haben sich binnen zwei Jahren vier Pferde mit einer sehr seltenen tödlichen Vireninfektion angesteckt. Die Tiere seien alle in der gleichen oberösterreichischen Region an den Bornaviren - Kurzform BoDV - erkrankt, teilte die Veterinärmedizinische Universität Wien mit. Die Borna-Krankheit führt zu tödlichen Entzündungen des Gehirns und des Rückenmarks vor allem bei Pferden und Schafen.
Über ihre Ergebnisse berichten die Forscher um Herbert Weissenböck vom Institut für Pathologie und gerichtliche Veterinärmedizin im Fachjournal "Ermerging Microbes & Infections". Sie sprechen von einem "neuen inländischem Endemiegebiet". Es handle sich um den ersten Ausbruch in dem bisher nicht betroffenen Gebiet. Es sei überraschend, dass die Krankheit dort ausgebrochen sei, sagte Weissenböck. Erkranke ein Tier, sei es nicht zu retten. "Eine Heilung gibt es nicht."
Bornaviren offenbar nicht gefährlich für den Menschen
Für Menschen besteht nach jüngsten Experteneinschätzungen wohl keine Gefahr. Noch vor einigen Jahren hatten Forscher angenommen, dass die Viren Depressionen verursachen können. "Wir sehen keinerlei Indizien dafür, dass dem wirklich so ist", sagte Weissenböck.
Tests an regionalen Feldspitzmäusen - dem einzigen bekannten Zwischenwirt - bestätigten den Verdacht auf ein lokales Virusreservoir: Rund die Hälfte der untersuchten Tiere war mit dem Erreger infiziert. Betroffene Mäuse tragen das Virus ihr Leben lang in sich, zeigen aber keine Symptome. Erstmals wurde auch eine Waldspitzmaus positiv getestet. "Bislang galt diese Art nicht als möglicher Träger der Bornaviren", hieß es.
Nager als Zwischenwirt
In Mitteleuropa tritt die Borna-Krankheit sporadisch immer wieder mal auf. Die oberösterreichischen Bornaviren seien genetisch nicht mit jenen aus dem nahen Bayern, sondern mit einem Virusstamm aus Rheinland-Pfalz am nächsten verwandt, berichten die Forscher. Wie sich das Virus künftig weiter ausbreiten könnte, sei unklar, sagte Weissenböck. "Die Spitzmäuse dürften aber sehr stark territorial gebunden sein."
Das BoD-Virus ist verwandt mit den Erregern von Tollwut und Masern. Vor rund zwei Jahren berichteten Experten, dass ein neuer, bei Bunthörnchen auftretender Erreger auf den Menschen übertragbar und offenbar für den Tod von drei Züchtern aus Sachsen-Anhalt in den Jahren 2011 bis 2013 verantwortlich ist. Diese Bornaviren mit der Bezeichnung VSBV-1 unterscheiden sich erheblich von den bisher bekannten Bornaviren und wurden als eigene Virusart eingestuft.